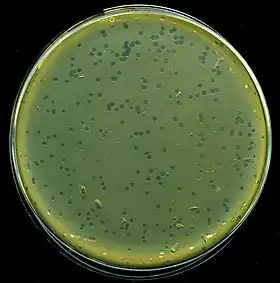

Fago λ
El fago λ o bacteriófago lambda es un virus bacteriófago que infecta a la bacteria Escherichia coli; descubierto en 1950 por Esther Lederberg.[1]
| Enterobacteria phage λ | ||
|---|---|---|
Placas de lisado de fagos lambda en la bacteria E. coli. | ||
| Taxonomía | ||
| Dominio: | Duplodnaviria | |
| Clase: | Caudoviricetes | |
| Familia: | Drexlerviridae | |
| Género: | Lambdavirus | |
| Especie: | λ Phage | |
| Clasificación de Baltimore | ||
| Grupo: | I (Virus ADN bicatenario) | |
El Fago λ igualmente es utilizado como un Vector de clonación.
Descripción
Se trata de un virus complejo de ADN lineal bicatenario. Los extremos de su material genético son cohesivos y ello hace que tras la infección su genoma se haga circular, comportándose, en caso de seguir un ciclo lisogénico, como un plásmido y aprovechando las enzimas de la recombinación de la bacteria para integrarse en el genoma de esta. El fago no tiene por qué integrarse, y de hecho es más habitual que se comporte como un virus de ciclo lítico.
- En el ciclo lisogénico, el virus utiliza las enzimas de la recombinación (véase intermedio de Hollyday) para insertarse en un punto concreto del genoma de la bacteria. En este estado, el virus se replica cuando lo hace la bacteria, pasando su genoma a las réplicas de E. coli. Además, una bacteria que posea ya un fago integrado no puede integrar otro, ya que el virus se introduce en un lugar concreto del cromosoma bacteriano.
El virus sintetiza a partir de su genoma el represor CI, que inhibe la expresión del resto de sus genes. En condiciones de estrés celular, la bacteria activa el sistema de respuesta SOS. Una de las enzimas que intervienen en la respuesta, RecA (que también interviene en la recombinación) actúa inhibiendo la actividad del represor CI, lo que desemboca una respuesta en cascada que hace que el virus integrado pase a la vía lítica.
- El ciclo lítico es la forma más habitual de actuación del virus al infectar la célula y también es la vía que sigue al final del ciclo lisogénico. En ella se producen partículas virales que son liberadas al medio una vez que la bacteria hospedadora es lisada, matando a la bacteria en el proceso.
El virus replica su genoma circular empezando por un punto de éste, y desenrollando sólo una de las dos hebras. El resultado es un genoma lineal muy largo, consistente en una gran cantidad de repeticiones del genoma original de forma seguida, lo que se conoce como concatémero. El virus también sintetiza las proteínas de su cápsida, y se ensambla en el citoplasma de la bacteria. Finalmente, la célula es lisada, liberando los viriones al medio.
Referencias
- Esther Lederberg, "Lysogenicity in Escherichia coli strain K-12, Microbial Genetics Bulletin, v.1, pp. 5-8 (Jan. 1950); seguido por "Lysogenicity in E. coli K-12", Genetics, v.36, p. 560 (1951) (abstract).